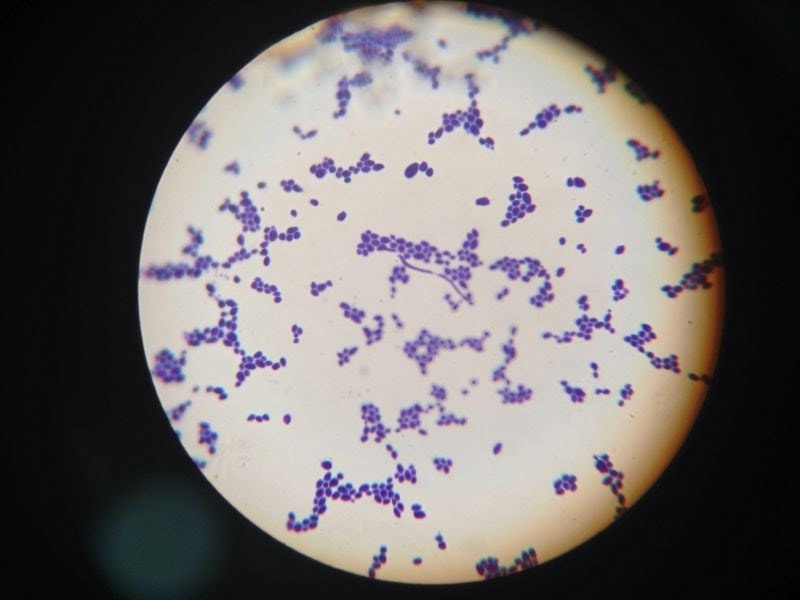
bacteria on a petri dish

One of the conditions we're constantly asked about is if probiotics can help in cases of Candida albicans yeast overgrowth, commonly known as Candidiasis or fungal dysbiosis. We'd say that it's very important that all Candida diet and supplement protocols are undertaken with the support and guidance of a suitably qualified therapist. Many symptoms of Candida overgrowth are similar to those relating to other health conditions, so it is also essential for individuals to first consult with their doctor to rule out other medical causes for their symptoms.
How do probiotics help with Candida?
Probiotics can help with Candida overgrowth in various ways, depending on the individual properties of that specific probiotic strain. Some strains can help to inhibit the growth of Candida, others can help to prevent Candida from colonising the gastrointestinal tract, whilst others can produce anti-fungal substances effective against Candida. These strains are discussed in more detail below.
Candida albicans - the silent predator
Which are the best probiotics for Candida?
As Candida yeasts are natural residents of the human body, doctors are often reluctant to offer allopathic support unless the condition manifests as obvious fungal infections such as thrush. Even then, their arsenal is limited to anti-fungal medicines, though it's been encouraging to note that some doctors are now suggesting that their patients consider natural supplements including probiotics.
It is very important to select the right strain for the right condition, however, and so it’s best to use those products containing species and strains that have been well-researched and shown to help discourage and address Candida overgrowth. To find out more about probiotic strains and what exactly a 'strain' is, see this article What are Probiotics?, over in the Probiotics Learning Lab.
The best probiotics for Candida include:
Saccharomyces boulardii
Lactobacillus acidophilus NCFM®
Lactobacillus rhamnosus GR-1®
Lactobacillus reuteri RC-14®
The first is Saccharomyces boulardii, which is itself a yeast, but one with probiotic potential which has displayed anti-Candida properties in relevant research studies. S. boulardii has been shown to inhibit populations of Candida and deter them from establishing in the intestines1, and it's also suggested that S. boulardii may help to reduce the risk of Candida yeasts translocating from the digestive tract2 . It's thought that these effects occur because S. boulardii produces caprylic acid, an antifungal substance which is effective against Candida yeasts3. S. boulardii has also been shown to reduce the potential for Candida infestation and inflammation in inflammatory bowel disease4.
Beneficial bacteria can also help to displace Candida populations; in particular, one of the most well-researched strains of Lactobacilli, Lactobacillus acidophilus NCFM®, has been shown in studies to stimulate the production of antibodies to C. albicans antigens7. A review of studies on Lactobacillus probiotics against candida showed several species to have the potential action to inhibit the growth and quantity of colony-forming units of Candida species in vitro studies11.

Saccharomyces boulardii - yeast against yeast
The following probiotic support has been recommended:
The dosage varies from person to person actually but the best thing to do is to start off with a low dose and gradually increase. This helps to reduce the possibility of a 'die-off' reaction (for more information about 'die-off' reactions see specific section at the bottom of this article).
However you may find that sufferers don't need to reach 6 capsules a day, and that 3-4 work fine to reduce symptoms. It is advised that patients stay on this dose for a number of weeks/ months until you feel the Candida has sufficiently left the system, or until the appropriate tests have confirmed this. Just to note – it is recommended that you take S. boulardii away from other anti-fungals (2 hours gap should be enough).
NB: Please recommend that clients should check with their doctor before using this supplement during pregnancy or whilst breast-feeding.
S. boulardii is a transient probiotic, meaning it does not take up residence within the gut, so a high quality daily probiotic containing well researched strains such as Lactobacillus acidophilus NCFM® is recommended. In this way, at the same time that the S. boulardii is helping to eradicate the pathogenic yeast, the friendly bacteria in a high quality daily probiotic can come in and repopulate the areas where the Candida once inhabited, and help to restore the balance of intestinal flora. This will hopefully reduce the risk of Candida overgrowth re-occurring and will re-enforce the mucosal lining of the gut – a vital part of the immune defences.

Taking a regular dose of probiotics could help with Candida
Saccharomyces boulardii:
Start with 1 capsule twice a day (morning and evening) for the first week.
Increase to 2 capsules twice daily for the second week.
By the third week increase to 2 capsules three times daily.
A high quality daily probiotic
1-2 capsules daily with breakfast
Other helpful probiotics for Candida symptoms
As constipation can sometimes be an issue for sufferers, it can be helpful to start off the programme by trying to improve regularity in patients, particularly as S. boulardii can sometimes cause constipation at high doses. For this a combination of Bifidobacterium lactis BB-12® and Fructooligosaccharides (FOS) might be advisable. B. lactis BB-12® has recently been the subject of one of the world’s largest clinical trials on probiotics, and has been found to promote regular bowel movements.
Vaginal thrush can be an unpleasant and persistent manifestation of Candida infection for many women. Two strains of probiotics have over 30 years of scientific evidence to support their use – Lactobacillus rhamnosus GR-1® and Lactobacillus reuteri RC-14®. These two strains are different to our other probiotics in that they have been shown to colonise in the vaginal tract rather than the intestines. They have been clinically trialled by over 2,500 women who found the combination to be helpful in managing the symptoms of thrush as well as helping to discourage future infections. To find out more about probiotics for thrush, plesae take a look at our article 'Which probiotics help with thrush?'.
Are any probiotics NOT recommended for Candida?
In general, there aren’t any probiotics that are contraindicated in Candida overgrowth; in fact, most probiotic bacteria offer some degree of anti-Candida potential through competitive inhibition and by lowering the pH in the intestines; like most pathogens, this troublesome yeast prefers an alkaline environment. There is some debate over whether an anti-Candida protocol should include prebiotics, in the form of fructo-oligosaccharides (FOS) or inulin, though as long as the prebiotics are of a high-quality source, the benefits of including these at the start of the programme can outweigh any potential they have to 'feed' the pathogenic yeast. If you are interested in finding out more about the debate you can read our blogpost, 'Does FOS feed bad bacteria?'
Candida In-depth
How does Candida become a health issue?
The Candida genus of yeasts is very large and includes many different species, though C. albicans is the most common offender in human fungal infections. The ‘Candida’ genus has many different species, but Candida albicans is the most common species to proliferate and cause health issues, though others, such as C. glabrata and C. auris are increasing in prevalence. Candida is a natural resident in our intestinal tract, and normally our own defence mechanisms help to keep it in check; however, stress, illness, medications such as antibiotics and a high intake of sugary foods can create conditions favourable for the yeast to proliferate. (Candida is a mould that feeds on other moulds). Even environment is important to reduce the mould count in houses, schools etc. and thrives in dark moist places so our bodies provide a multitude of potential hang-outs for this opportunistic yeast.
Once it has taken hold, Candida can then be a challenge to manage and overcome. Conventional treatments include anti-fungals such as Clotrimazole, which can initially help symptoms, but Candida is a survivor and can retreat deep into body tissues when faced with anti-fungals, lying dormant there until conditions for its survival improve.This is why it can sometimes take a combination of prescription or natural anti-fungals, appropriate dietary interventions and supplements, and effective probiotics to finally put this pathogen back in its place. It's also why some therapists believe that it's best not to eradicate all potential food sources for the yeast from the patient's diet, believing that it's better to just reduce intake of these foods instead to keep the yeast 'living', albeit in a less powerful form, in order for it to be displaced and eradicated.

Alcohol is typically prohibited on an anti-Candida protocol
On the whole, however, anti-Candida diets typically exclude processed, high-sugar foods, some fruits, and 'yeasty' foods and drinks like bread and alcohol which are all thought to promote the growth of this pathogen, and any foods to which the patient may have become intolerant. A gut-healing, immunity-supporting diet is desirable, along with foods that can help to naturally suppress Candida and promote the growth of beneficial bacteria - coconut oil contains caprylic acid so can be a useful addition, as can olive oil, garlic, onions and ginger for their anti-fungal and prebiotic potential.
How do you know if you have Candidiasis?
Symptoms of this yeast overgrowth can manifest in such a wide variety of ways that it can sometimes be as tricky to identify as to address, and so in the first instance, any undiagnosed symptoms should first be discussed with a doctor, or that the appropriate clinical tests be conducted.
Potential Candida overgrowth can be associated with a history of high sugar/fruit consumption; severe stress; taking antibiotic/steroid/birth control medication or even prolonged exposure to mould-ridden environments. The symptoms which make a fungal overgrowth easy to identify include thrush (vaginal or oral) or other fungal infections such as athlete’s foot, but the broader range of Candida-related symptoms can include diarrhoea/constipation, bloating, belching, rectal itching, food intolerances, and a propensity towards stomach upsets. Other health conditions thought to have their basis in Candida overgrowth are chronic fatigue syndrome, acne/eczema, headaches, mental disorders such as anxiety, confusion and ‘foggy brain’ and many other chronic health complaints.Another harmful side effect of Candida overgrowth can be intestinal permeability ('leaky gut'), as the yeasts burrow into and compromise the delicate intestinal mucosa. Symptoms of this can manifest as generalised inflammation, skin rashes and other allergic symptoms. In this way, Candida can eventually leach through into the bloodstream and become systemic, affecting body organs and other areas beyond the digestive system. The mycotoxins that the yeasts excrete can then even cross the blood brain barrier and this is how the mental symptoms such as confusion (often described as ‘foggy brain’) and anxiety can develop. Probiotics can help with leaky gut caused by Candida by re-enforcing the lining of the gut. This also helps to prevent gaps from forming in the space between the enterocytes which lead to increased intestinal permeability.

Systemic candida is thought to cause headaches, mood disturbances and mental health issues
What are ‘die-off’ reactions?
‘Die-off’ reactions, sometimes called the Jarisch–Herxheimer reaction after the European doctors who first noted the symptoms, are thought to occur as a result of a toxic overload in the body. When pathogenic bacteria and yeasts are displaced, either by antibiotics, anti-fungals, or probiotics, then they are believed to release up to 70 different types of toxic substances. If these pathogens are dying off in large numbers, then these toxins can be difficult for the body to eliminate, particularly where pathways of elimination may be compromised6.
Could probiotics help with C. auris?
While probiotics have shown promise in managing Candida albicans overgrowth by restoring microbiome balance and inhibiting fungal colonisation, their effectiveness against Candida auris remains unclear. C. auris is a highly resistant, hospital-associated pathogen that thrives in healthcare settings, often forming biofilms on medical devices and surfaces rather than colonizing the gut or mucosal linings like C. albicans. Some probiotic strains have demonstrated antifungal properties and biofilm disruption against other Candida species, but there is limited research on their impact specifically on C. auris.
What is the difference between Candida and SIFO?
This question can cause some confusion because Small Intestinal Fungal Overgrowth (SIFO) has been shown to be caused primarily by Candida Albicans12. Candida species is a fungi that naturally occurs in the human body, but when the immune system is lowered in some way, then Candida can overtake commensal bacteria in higher numbers, leading to overgrowth. This type of overgrowth has been found in immunocompromised people with HIV, as well as people under steroid, antibiotic therapy, cancer patients and diabetes13. Other potential causes PPI therapy and dysmotility of the small intestine. Consumption of food commodities that have been contaminated by naturally occurring mycotoxins can be a trigger too.
Summary
It's important that patients understand that any anti-Candida protocol is not a permanent fix that will prevent this troublesome yeast from causing future health issues. Maintaining a healthy diet and lifestyle is essential, but as our intestinal flora form a key part of our immune system defences against this pathogen, it's also very important to maintain a healthy gut microbiota as our intestinal environment is constantly evolving.










